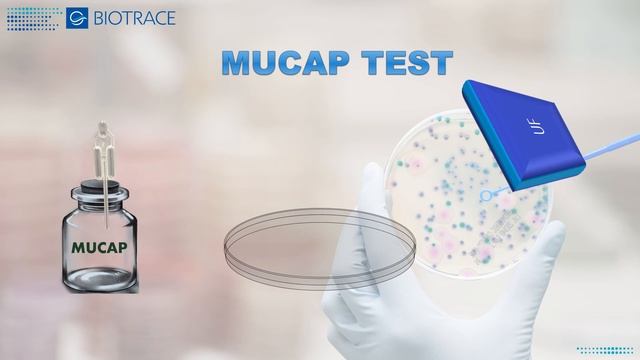
Поживні середовища від БІОТРЕЙС смотреть онлайн

Автор: Шеф-повар дома Страница 5

리얼먹방:) 베이컨토마토디럭스,1955버거,치킨너겟 ★ 햄버거는 밤에 먹어야 제맛ㅣBurger & Chicken NuggetㅣREAL SOUNDㅣASMR MUKBANGㅣ

Солодовые экстракты Inpinto на 9-18 литров

Сколько жители Орска потратили денег, чтобы собрать ребёнка в школу

Юбка в стиле БОХО.

ПЕРВЫЙ СНЕГ! ДРИФТ ОТ ПЕРВОГО ЛИЦА! КАТАЕМ НА ТОГЭ ?

Корзина с цветами из холодного фарфора | NEO-Inspiration

Я вам покажу как отправить ссылку на канвл через ватцап

Отбивные из куриного филе.

Согласование проекта задания на проектирование объектов капитального строительства Жихарева Т А

СУП 9: Ирина Кеня

Глаголы в иврите. Глаголы 101-109. Учимся спрягать глаголы.

Медицинский перевод: особенности и стоимость
![[Mukbang ASMR] 레전드! 16KG 역대급 초대왕 문어 먹방? 16KG Biggest Octopus Eatingshow realsound Ssoyoung смотреть онлайн](https://pic.rutubelist.ru/video/c2/79/c2798f0182e3a99170e1c929fa94c2da.jpg?size=m)
[Mukbang ASMR] 레전드! 16KG 역대급 초대왕 문어 먹방? 16KG Biggest Octopus Eatingshow realsound Ssoyoung

День Бухгалтера та аудитора України

Как сделать мыло при домашних условиях. Часть 2.

в доме на Юге не только заросли ТРАВЫ

Играю в игру Мой Ресторан???Делаем разные вкусности???????

НЕОБЫЧНАЯ ИДЕЯ ИЗ СТЕКЛЯННОЙ БАНКИ ? ПОТРЯСАЮЩИЙ ФОНАРЬ ДЛЯ ДОМА СВОИМИ РУКАМИ DIY
Поживні середовища від БІОТРЕЙС

как приготовить верблюжье мясо

Рецепт молочного коктейля от Алены.

Цветные Пельмешки

Кипр - пляжный коктейль Востока и Запада

laly27Vera#games#trucos ya listo la 4ta puerta y vamos por la 5ta
За каждым успешным каналом стоит личность, идея и сотни часов кропотливого труда. Если вы здесь, значит, автор «Шеф-повар дома» уже сумел зацепить ваше внимание своим уникальным стилем или подачей. А мы на RUVIDEO позаботились о том, чтобы вы могли изучить весь архив его работ в максимально комфортных условиях — без лишней суеты и преград.
Почему за работами канала «Шеф-повар дома» так интересно наблюдать? Всё просто: это честный контент, который находит отклик в сердцах зрителей. На нашем ресурсе вы можете смотреть онлайн все видео любимого автора бесплатно и в хорошем качестве. Нам важно, чтобы вы видели каждую деталь и слышали каждый нюанс, поэтому мы используем только стабильные плееры из открытых источников Rutube.
Следите за новинками канала, пересматривайте старые шедевры и открывайте для себя новые грани творчества «Шеф-повар дома». Мы постоянно обновляем ленту, чтобы у вас под рукой всегда были самые свежие выпуски. Никаких сложных регистраций — только вы и творчество, которое вдохновляет. Приятного вам путешествия по миру авторского контента на RUVIDEO!
Видео взято из открытых источников Rutube. Если вы правообладатель, обратитесь к первоисточнику.